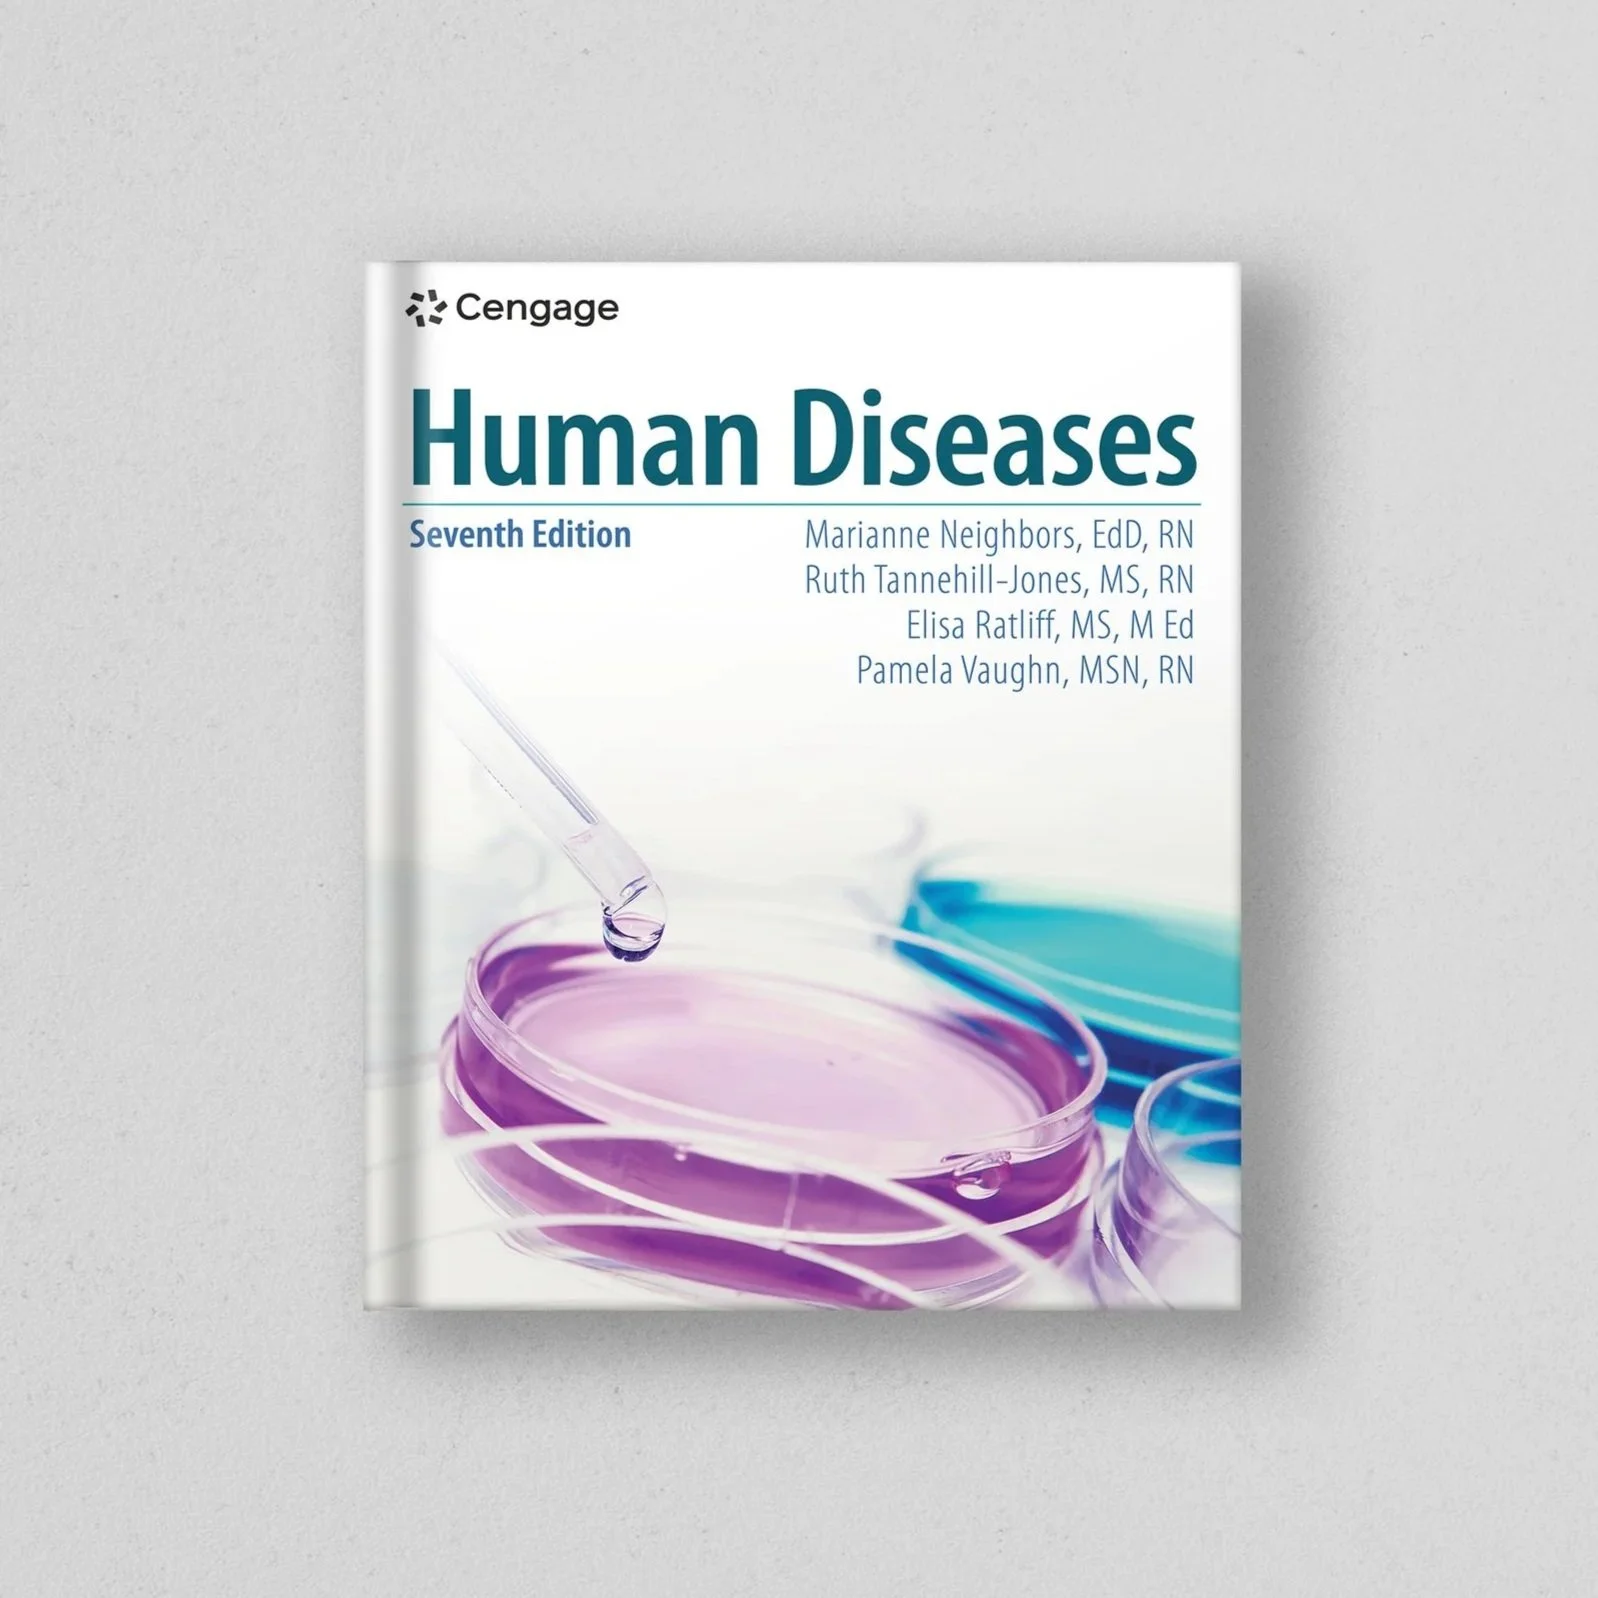

Cover Design – Cengage
Role Summary:
While at Cengage, I created approximately 120 cover designs across a diverse range of subject areas. My primary responsibility was to develop visually engaging and conceptually accurate solutions that effectively represented each book's content and academic focus.
Key Subject Areas:
Criminal Justice
Health Professions
Automotive
Building Trades
Early Education
Business
Agriculture
Economics
English
Each design required a tailored approach to align with the discipline's tone, audience, and educational goals. This role demanded a strong ability to translate complex subject matter into compelling visual narratives that resonate with students and educators alike. These are my favorite designs from the collection.